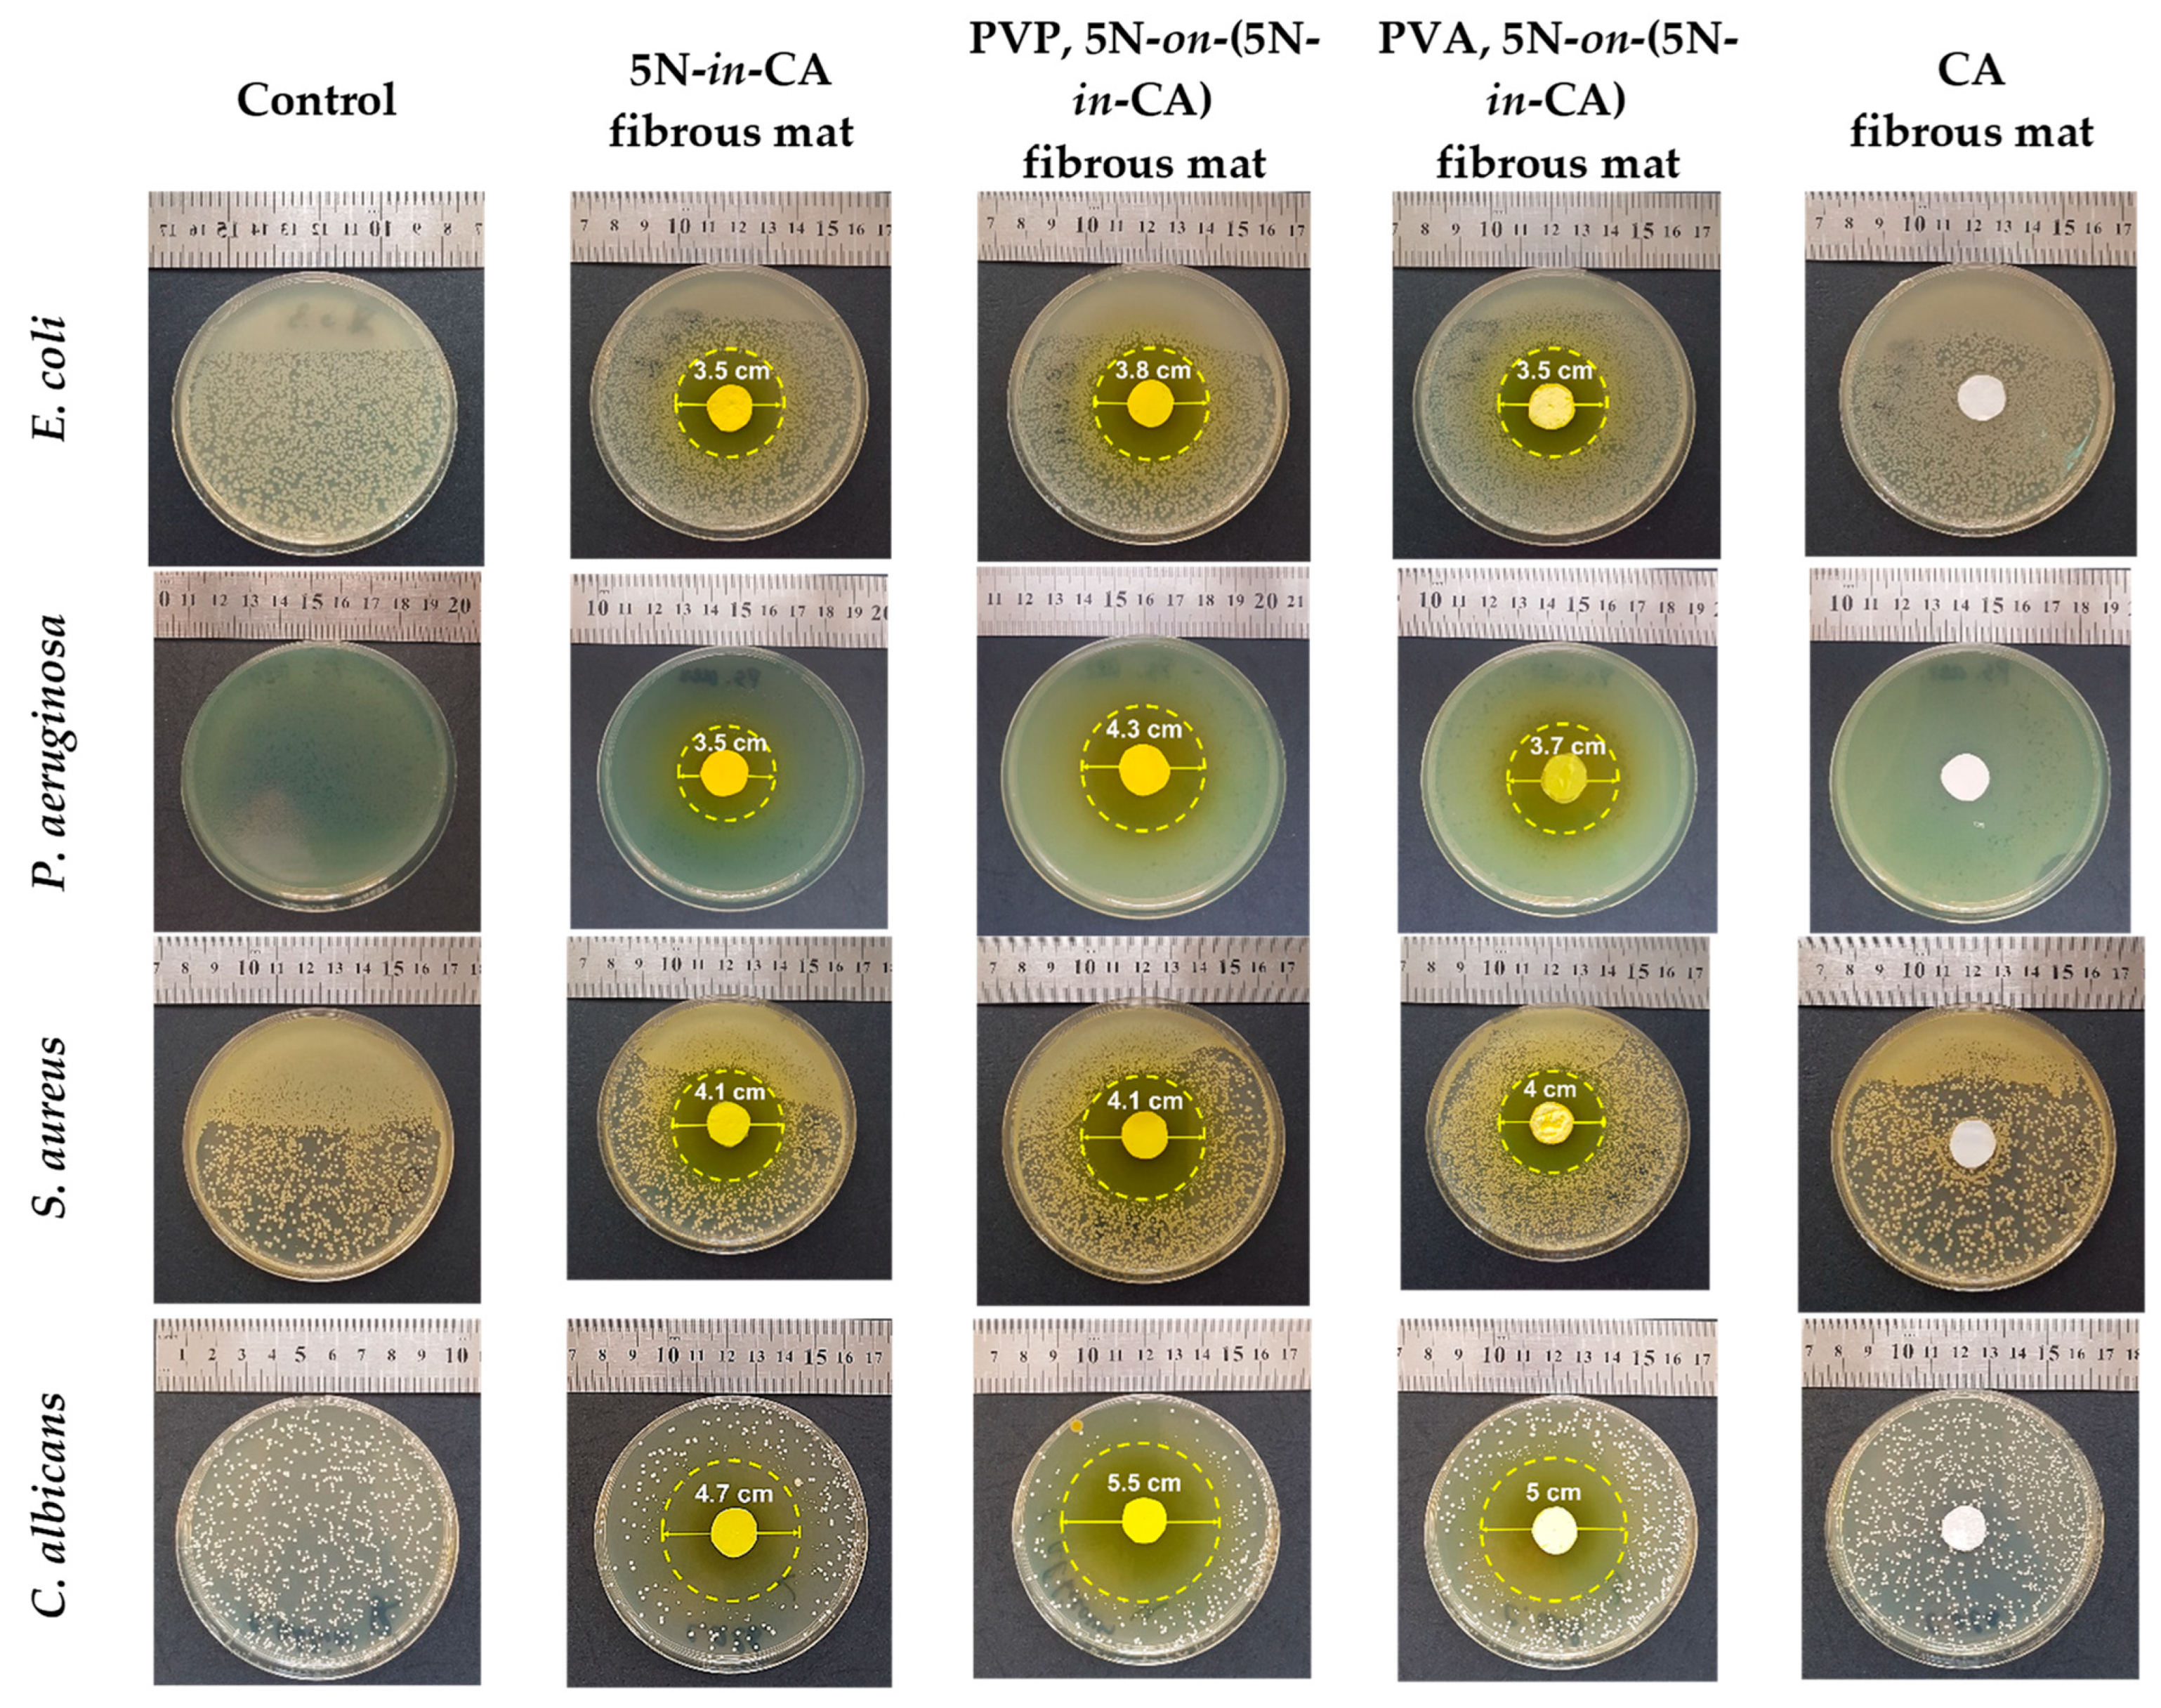
Antioxidants 12 01243 g008 Antioxidants 12 01243 g008

Innovative Fibrous Materials Loaded with 5-Nitro-8-hydroxyquinoline via Electrospinning/Electrospraying Demonstrate Antioxidant, Antimicrobial and Anticancer Activities
Abstract
1. Introduction
2. Materials and Methods
2.1. Materials
2.2. Preparation of Fibrous Materials via Electrospinning/Electrospraying
2.2.1. Preparation of CA and 5N-in-CA Mats
2.2.2. Preparation of PVP,5N-on-(5N-in-CA) and PVA,5N-on-(5N-in-CA) Mats via Electrospinning in Conjunction with Electrospraying
2.3. Characterization Methods
2.4. Antibacterial and Antifungal Assessments
2.5. Cytotoxicity Assessment by MTT Cell Viability Assay
2.6. Dual Staining with AO and EtBr for Studying Apoptotic Induction
2.7. DAPI Staining Assay
2.8. Statistics
3. Results
3.1. Preparation and Observation
3.2. XRD Pattern
3.3. FT-IR Studies
3.4. Water Contact Angle Measurements
3.5. Drug Release
3.6. Antioxidant Activity
3.7. Antibacterial and Antifungal Properties
3.8. In Vitro Cytotoxicity Assessment against Normal and Cancer Cell Lines
3.9. Study of Cell Death by Staining with AO and EtBr and DAPI
4. Conclusions
Supplementary Materials
Author Contributions
Funding
Institutional Review Board Statement
Informed Consent Statement
Data Availability Statement
Acknowledgments
Conflicts of Interest
References
- Reddy, V.S.; Tian, Y.; Zhang, C.; Ye, Z.; Roy, K.; Chinnappan, A.; Ramakrishna, S.; Liu, W.; Ghosh, R. A Review on electrospun nanofibers based advanced applications: From health care to energy devices. Polymers 2021, 13, 3746. [Google Scholar] [CrossRef] [PubMed]
- Islam, M.S.; Ang, B.C.; Andriyana, A.; Aff, A.M. A review on fabrication of nanofbers via electrospinning and their applications. SN Appl. Sci. 2019, 1, 1248. [Google Scholar] [CrossRef]
- Fadil, F.; Affandi, N.D.N.; Misnon, M.I.; Bonnia, N.N.; Harun, A.M.; Alam, M.K. Review on electrospun nanofiber-applied products. Polymers 2021, 13, 2087. [Google Scholar] [CrossRef] [PubMed]
- Xu, X.; Ren, S.; Li, L.; Zhou, Y.; Peng, W.; Xu, Y. Biodegradable engineered fiber scaffolds fabricated by electrospinning for periodontal tissue regeneration. J. Biomater. Appl. 2021, 36, 55–75. [Google Scholar] [CrossRef] [PubMed]
- Hong, J.; Yeo, M.; Yang, G.H.; Kim, G. Cell-electrospinning and its application for tissue engineering. Int. J. Mol. Sci. 2019, 20, 6208. [Google Scholar] [CrossRef]
- Farhaj, S.; Conway, B.R.; Ghori, M.U. Nanofibres in drug delivery applications. Fibers 2023, 11, 21. [Google Scholar] [CrossRef]
- Gaydhane, M.K.; Sharma, C.S.; Majumdar, S. Electrospun nanofibres in drug delivery: Advances in controlled release strategies. RSC Adv. 2023, 13, 7312–7328. [Google Scholar] [CrossRef]
- Wsoo, M.A.; Shahir, S.; Mohd Bohari, S.P.; Mat Nayan, N.H.; Abd Razak, S.I. A review on the properties of electrospun cellulose acetate and its application in drug delivery systems: A new perspective. Carbohydr. Res. 2020, 491, 107978. [Google Scholar] [CrossRef]
- Khoshnevisan, K.; Maleki, H.; Samadian, H.; Shahsavari, S.; Sarrafzadeh, M.H.; Larijani, B.; Dorkoosh, F.A.; Haghpanah, V.; Khorramizadeh, M.R. Cellulose acetate electrospun nanofibers for drug delivery systems: Applications and recent advances. Carbohydr. Polym. 2018, 198, 131–141. [Google Scholar] [CrossRef]
- Liang, W.; Hou, J.; Fang, X.; Bai, F.; Zhu, T.; Gao, F.; Wei, C.; Mo, X.; Lang, M. Synthesis of cellulose diacetate based copolymer electrospun nanofibers for tissues scaffold. Appl. Surf. Sci. 2018, 443, 374–381. [Google Scholar] [CrossRef]
- Puls, J.; Wilson, S.A.; Holter, D. Degradation of cellulose acetate-based materials: A review. J. Polym. Environ. 2011, 19, 152–165. [Google Scholar] [CrossRef]
- Suwantong, O.; Supaphol, P. Handbook of Polymer Nanocomposites; Processing, Performance and Application; Springer: Berlin/Heidelberg, Germany, 2015; pp. 355–368. [Google Scholar]
- Frey, M.W. Electrospinning cellulose and cellulose derivatives. Polym. Rev. 2008, 48, 378–391. [Google Scholar] [CrossRef]
- Aidana, Y.; Wang, Y.; Li, J.; Chang, S.; Wang, K.; Yu, D.-G. Fast dissolution electrospun medicated nanofibers for effective delivery of poorly water-soluble drug. Curr. Drug Deliv. 2022, 19, 422–435. [Google Scholar] [PubMed]
- Maslakci, N.N.; Ulusoy, S.; Uygun, E.; Çevikbaş, H.; Oksuz, L.; Can, H.K.; Oksuz, A.U. Ibuprofen and acetylsalicylic acid loaded electrospun PVP-dextran nanofiber mats for biomedical applications. Polym. Bull. 2017, 74, 3283–3299. [Google Scholar] [CrossRef]
- Shibata, T.; Yoshimura, N.; Kobayashi, A.; Ito, T.; Hara, K.; Tahara, K. Emulsion-electrospun polyvinyl alcohol nanofibers as a solid dispersion system to improve solubility and control the release of probucol, a poorly water-soluble drug. J. Drug Deliv. Sci. Technol. 2022, 67, 102953. [Google Scholar] [CrossRef]
- Tsekova, P.; Spasova, M.; Manolova, N.; Rashkov, I.; Markova, N.; Georgieva, A.; Toshkova, R. Electrospun cellulose acetate membranes decorated with curcumin-PVP particles: Preparation, antibacterial and antitumor activities. J. Mater. Sci. Mater. Med. 2018, 29, 9. [Google Scholar] [CrossRef]
- Yakub, G.; Toncheva, A.; Manolova, N.; Rashkov, I.; Danchev, D.; Kussovski, V. Electrospun polylactide-based materials for curcumin release: Photostability, antimicrobial activity, and anticoagulant effect. J. Appl. Polym. Sci. 2016, 133, 42940. [Google Scholar] [CrossRef]
- Wang, H.; Chu, C.; Hao, L.; She, Y.; Li, Y.; Zhai, L.; Jiang, S. Synthesis, antimicrobial, and release behaviors of tetracycline hydrochloride loaded poly(vInyl alcohol)/chitosan/ZrO2 nanofibers. J. Appl. Polym. Sci. 2015, 132, 42506. [Google Scholar] [CrossRef]
- Zhang, J.; Chen, K.; Ding, C.; Sun, S.; Zheng, Y.; Ding, Q.; Hong, B.; Liu, W. Fabrication of chitosan/PVP/dihydroquercetin nanocomposite film for in vitro and in vivo evaluation of wound healing. Int. J. Biol. Macromol. 2022, 206, 591–604. [Google Scholar] [CrossRef]
- Sun, S.; Hao, M.; Ding, C.; Zhang, J.; Ding, Q.; Zhang, Y.; Zhao, Y.; Liu, W. SF/PVP nanofiber wound dressings loaded with phlorizin: Preparation, characterization, in vivo and in vitro evaluation. Colloids Surf. B 2022, 217, 112692. [Google Scholar] [CrossRef]
- Viscusi, G.; Paolella, G.; Lamberti, E.; Caputo, I.; Gorrasi, G. Quercetin-loaded polycaprolactone-polyvinylpyrrolidone electrospun membranes for health application: Design, characterization, modeling and cytotoxicity studies. Membranes 2023, 13, 242. [Google Scholar] [CrossRef] [PubMed]
- Gupta, R.; Luxami, V.; Paul, K. Insights of 8-hydroxyquinolines: A novel target in medicinal chemistry. Bioorg. Chem. 2021, 108, 104633. [Google Scholar] [CrossRef] [PubMed]
- Al-Busafi, S.N.; Suliman, F.E.O.; Al-Alawi, Z.R. 8-Hydroxyquinoline and its derivatives: Synthesis and applications. Res. Rev. J. Chem. 2014, 3, 1–10. [Google Scholar]
- Tanzer, J.M.; Slee, A.M.; Kamay, B.; Scheer, E. Activity of three 8-hydroxyquinoline derivatives against in vitro dental plaque. Antimicrob. Agents Chemother. 1978, 13, 1044–1045. [Google Scholar] [CrossRef]
- Spasova, M.; Manolova, N.; Markova, N.; Rashkov, I. Superhydrophobic PVDF and PVDF-HFP nanofibrous mats with antibacterial and anti-biofouling properties. Appl. Surf. Sci. 2016, 363, 363–371. [Google Scholar] [CrossRef]
- Kyuchyuk, S.; Paneva, D.; Manolova, N.; Rashkov, I.; Karashanova, D.; Markova, N. Core/double-sheath composite fibers from poly(ethylene oxide), poly(L-lactide) and beeswax by single-spinneret electrospinning. Polymers 2022, 14, 5036. [Google Scholar] [CrossRef] [PubMed]
- Spasova, M.; Manolova, N.; Paneva, D.; Rashkov, I. Preparation of chitosan-containing nanofibres by electrospinning of chitosan/poly(ethylene oxide) blend solutions. e-Polymers 2004, 4, 1–12. [Google Scholar] [CrossRef]
- Spasova, M.; Manolova, N.; Rashkov, I.; Naydenov, M. Electrospun 5-chloro-8-hydroxyquinoline-loaded cellulose acetate/polyethylene glycol antifungal membranes against Esca. Polymers 2019, 11, 1617. [Google Scholar] [CrossRef] [PubMed]
- Spasova, M.; Manolova, N.; Rashkov, I.; Tsekova, P.; Georgieva, A.; Toshkova, R.; Markova, N. Cellulose acetate-based electrospun materials with a variety of biological potentials: Antibacterial, antifungal and anticancer. Polymers 2021, 13, 1631. [Google Scholar] [CrossRef] [PubMed]
- Ignatova, M.; Manolova, N.; Rashkov, I.; Markova, N.; Kukeva, R.; Stoyanova, R.; Georgieva, A.; Toshkova, R. 8-Hydroxyquinoline-5-sulfonic acid-containing poly(vinyl alcohol)/chitosan electrospun materials and their Cu2+ and Fe3+ complexes: Preparation, antibacterial, antifungal and antitumor activities. Polymers 2021, 13, 2690. [Google Scholar] [CrossRef]
- Ignatova, M.; Stoilova, O.; Manolova, N.; Markova, N.; Rashkov, I. Electrospun mats from styrene/maleic anhydride copolymers: Modification with amines and assessment of antimicrobial activity. Macromol. Biosci. 2010, 10, 944–954. [Google Scholar] [CrossRef] [PubMed]
- Ignatova, M.; Stoyanova, N.; Manolova, N.; Rashkov, I.; Kukeva, R.; Stoyanova, R.; Toshkova, R.; Georgieva, A. Electrospun materials from polylactide and Schiff base derivative of Jeffamine ED® and 8-hydroxyquinoline-2-carboxaldehyde and its complex with Cu2+: Preparation, antioxidant and antitumor activities. Mater. Sci. Eng. C 2020, 116, 111185. [Google Scholar] [CrossRef] [PubMed]
- Ignatova, M.; Anastasova, I.; Manolova, N.; Rashkov, I.; Markova, N.; Kukeva, R.; Stoyanova, R.; Georgieva, A.; Toshkova, R. Bio-based electrospun fibers from chitosan schiff base and polylactide and their Cu2+ and Fe3+ complexes: Preparation and antibacterial and anticancer activities. Polymers 2022, 14, 5002. [Google Scholar] [CrossRef] [PubMed]
- Rasband, W.S. ImageJ, US National Institutes of Health, Bethesda, MD (1997–2021). Available online: http://imagej.nih.gov/ij (accessed on 3 January 2016).
- Mosmann, T. Rapid colorimetric assay for cellular growth and survival: Application to proliferation and cytotoxicity assays. J Immunol. Methods. 1983, 65, 55–63. [Google Scholar] [CrossRef] [PubMed]
- Tsekova, P.; Spasova, M.; Manolova, N.; Markova, N.; Rashkov, I. Electrospun curcumin-loaded cellulose acetate/polyvinylpyrrolidone fibrous materials with complex architecture and antibacterial activity. Mater. Sci. Eng. C 2017, 73, 206–214. [Google Scholar] [CrossRef]
- Cherdtrakulkiat, R.; Boonpangrak, S.; Sinthupoom, N.; Prachayasittikul, S.; Ruchirawat, S.; Prachayasittikul, V. Derivatives (halogen, nitro and amino) of 8-hydroxyquinoline with highly potent antimicrobial and antioxidant activities. BB Rep. 2016, 6, 135–141. [Google Scholar] [CrossRef]
- Faydy, M.; Djassinra, T.; Haida, S.; Rbaa, M.; Ounine, K.; Kribii, A.; Lakhrissi, B. Synthesis and investigation of antibacterial and antioxidants properties of some new 5-subsituted-8-hydroxyquinoline derivatives. J. Mater. Environ. Sci. 2017, 8, 3855–3863. [Google Scholar]
- Pippi, B.; Lopes, W.; Reginatto, P.; Silva, F.; Joaquim, A.; Alves, R.; Silveira, G.; Vainstein, M.; Andrade, S.; Fuentefria, A. New insights into the mechanism of antifungal action of 8-hydroxyquinolines. Saudi Pharm. J. 2019, 27, 41–48. [Google Scholar] [CrossRef]

Disclaimer/Publisher’s Note: The statements, opinions and data contained in all publications are solely those of the individual author(s) and contributor(s) and not of MDPI and/or the editor(s). MDPI and/or the editor(s) disclaim responsibility for any injury to people or property resulting from any ideas, methods, instructions or products referred to in the content. |
© 2023 by the authors. Licensee MDPI, Basel, Switzerland. This article is an open access article distributed under the terms and conditions of the Creative Commons Attribution (CC BY) license (https://creativecommons.org/licenses/by/4.0/).
Share and Cite
Spasova, M.; Stoyanova, N.; Nachev, N.; Ignatova, M.; Manolova, N.; Rashkov, I.; Georgieva, A.; Toshkova, R.; Markova, N. Innovative Fibrous Materials Loaded with 5-Nitro-8-hydroxyquinoline via Electrospinning/Electrospraying Demonstrate Antioxidant, Antimicrobial and Anticancer Activities. Antioxidants 2023, 12, 1243. https://doi.org/10.3390/antiox12061243
Spasova M, Stoyanova N, Nachev N, Ignatova M, Manolova N, Rashkov I, Georgieva A, Toshkova R, Markova N. Innovative Fibrous Materials Loaded with 5-Nitro-8-hydroxyquinoline via Electrospinning/Electrospraying Demonstrate Antioxidant, Antimicrobial and Anticancer Activities. Antioxidants. 2023; 12(6):1243. https://doi.org/10.3390/antiox12061243
Chicago/Turabian StyleSpasova, Mariya, Nikoleta Stoyanova, Nasko Nachev, Milena Ignatova, Nevena Manolova, Iliya Rashkov, Ani Georgieva, Reneta Toshkova, and Nadya Markova. 2023. "Innovative Fibrous Materials Loaded with 5-Nitro-8-hydroxyquinoline via Electrospinning/Electrospraying Demonstrate Antioxidant, Antimicrobial and Anticancer Activities" Antioxidants 12, no. 6: 1243. https://doi.org/10.3390/antiox12061243
APA StyleSpasova, M., Stoyanova, N., Nachev, N., Ignatova, M., Manolova, N., Rashkov, I., Georgieva, A., Toshkova, R., & Markova, N. (2023). Innovative Fibrous Materials Loaded with 5-Nitro-8-hydroxyquinoline via Electrospinning/Electrospraying Demonstrate Antioxidant, Antimicrobial and Anticancer Activities. Antioxidants, 12(6), 1243. https://doi.org/10.3390/antiox12061243

